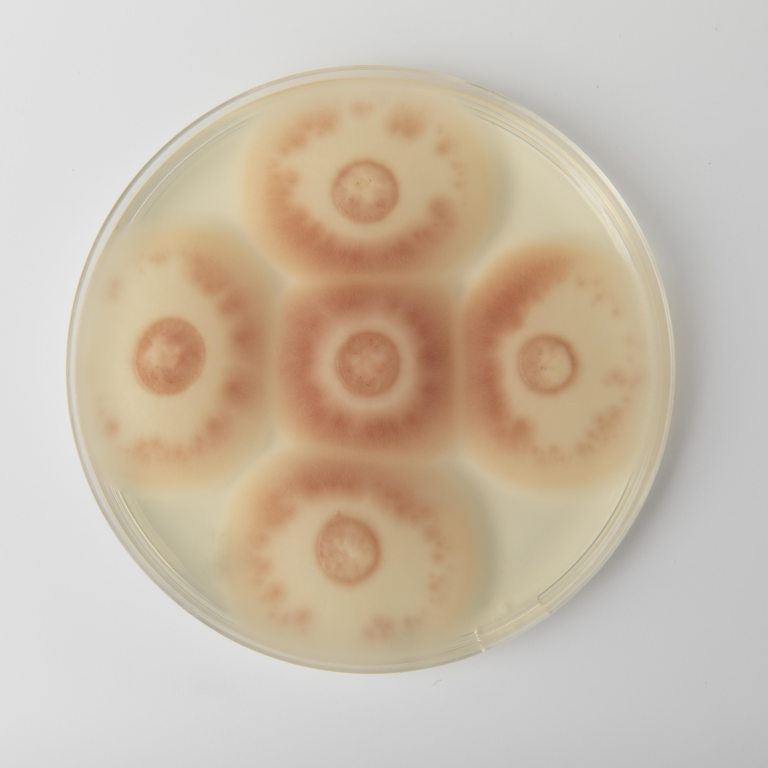

Developing microbial oil dispersion (OD) formulations
This datasheet introduces four OD chassis systems for microbial formulation development. Recipes, methods and initial compatibility data are all provided.
数据表 (英语)
资料语言选择: 英语
资料形式: PDF
资料大小: 571.0 KB